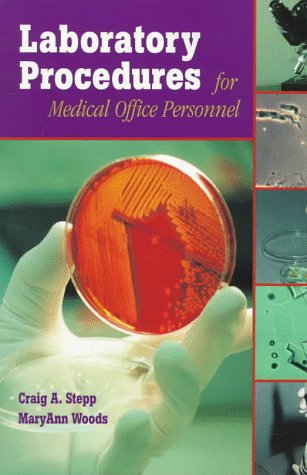
Laboratory Procedures for Medical Office Personnel, 1e

Laboratory Procedures for Medical Office Personnel, 1e Book PDF, ePub eBook
Laboratory Procedures for Medical Office Personnel, 1e.pdf
File Name: Laboratory Procedures for Medical Office Personnel, 1e.pdf
Size: 24.15 MB
Uploaded: 2017-06-16 04:11:10


